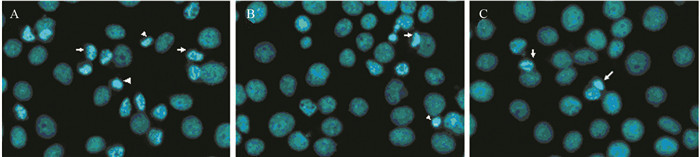

文章信息
- 沉默FANCD2对人头颈鳞癌SIHN-005A细胞化疗敏感度的影响及其机制
- Effects and Mechanisms of FANCD2 Knock Down on Chemotherapy Sensitivity of Head and Neck Squamous Cell Carcinoma Cells SIHN-005A
- 肿瘤防治研究, 2017, 44(3): 162-167
- Cancer Research on Prevention and Treatment, 2017, 44(3): 162-167
- http://www.zlfzyj.com/CN/10.3971/j.issn.1000-8578.2017.03.002
- 收稿日期: 2016-07-20
- 修回日期: 2016-09-19
头颈部肿瘤是临床上常见的恶性肿瘤,现有手术加放化疗的综合治疗模式中,晚期肿瘤患者对化疗药物不敏感是导致治疗失败的重要原因。因此寻找肿瘤增敏的靶基因是提高肿瘤化疗药物敏感度亟需解决的问题。范可尼贫血(fanconi anemia, FA)作为一种由于基因突变而导致的DNA损伤修复功能障碍、染色体脆性增加的隐性遗传病,主要以先天畸形、进行性骨髓衰竭及肿瘤易患性为临床表现。研究发现自FA患者分离出的细胞对电离辐射及DNA交联剂如丝裂霉素C、CDDP等敏感[1]。其机制主要是FA通路失活所导致的DNA链间交联损伤修复障碍[2]。FANCD2作为FA通路中的关键蛋白,它的单泛素化或去泛素化障碍均能导致FA通路的失活继而增加细胞对DNA交联剂的敏感度[3-4]。本研究通过观察shRNA沉默FANCD2基因对人HNSCC SIHN-005A细胞CDDP作用后体外生长、凋亡、细胞周期改变的影响,同时从蛋白水平检测细胞周期蛋白Cyclin D1、凋亡相关蛋白Bax/Bcl-2、乏氧诱导因子HIF-1α蛋白表达的变化,探讨FANCD2基因沉默对人HNSCC SIHN-005A细胞CDDP敏感度的影响及可能机制。
1 材料与方法 1.1 材料 1.1.1 细胞株实验组含有效FANCD2 shRNA干扰序列的人HNSCC细胞SIHN-005A(shRNA组)、含无效干扰序列的SIHN-005A阴性对照组细胞(shRNA-C组)及野生型SIHN-005A空白对照组细胞株(Control组),由西南医科大学附属医院耳鼻咽喉头颈外科覃纲博士在英国牛津大学Weatherall分子医学研究所Stephan M. Feller博士研究小组实验获得。
1.1.2 实验材料鼠抗人单克隆抗体FANCD2、单克隆鼠抗人Bax抗体均购自美国Santa Cruz公司;单克隆鼠抗人Cyclin D1抗体、单克隆鼠抗人HIF-1α抗体均购自美国Abcam公司;单克隆兔抗人Bcl-2抗体购自美国Aspl75公司;单克隆β-actin抗体、顺铂(CDDP)及CCK-8(cell counting kit-8)试剂盒均购自美国Sigma公司;Hoechst染色试剂盒、Western blot试剂盒均购自上海碧云天公司。
1.2 方法 1.2.1 细胞培养和筛选含10%胎牛血清(FCS)、青霉素100 u/ml和链霉素100 μg/ml的DMEM培养液,置于37℃、含5%CO2的饱和湿度恒温培养箱中培养。细胞培养及种板过程中以嘌呤霉素作为筛选试剂,加入到shRNA组和shRNA-C组细胞中维持筛选,连续传代、扩大培养。
1.2.2 Western blot检测FANCD2沉默效应取对数生长期三组细胞,分别提取细胞总蛋白,加入适量浓缩的SDS-PAGE蛋白上样缓冲液,100℃水浴加热3~5 min,使蛋白充分变性。采用Bradford法测定蛋白浓度,等量加样。行12%SDS-PAGE电泳,通过电转移印迹到PVDF膜上,Western封闭液室温封闭90 min,4℃过夜。加入1:300稀释度的FANCD2一抗,室温孵育1 h。加入1:600稀释度的二抗,室温孵育1 h。加入BeyoECL发光液,避光显色至出现条带时放入双蒸水终止反应。放入KODAK Image Station2000MM Digital Imaging System曝光获取图像,分别分析灰度值,比较各组蛋白表达量。
1.2.3 细胞药物敏感度实验(CCK-8比色法)取对数生长期细胞以4 000个每孔接种于96孔板。培养24 h待细胞贴壁后分别加入CDDP至终浓度为1、2、4、8及16 μg/ml,空白对照组仅加入100 μl 2.5% FCS DMEM培养液,再设置100 μl 2.5%FCS DMEM培养液做本底对照以校正OD值,每组3个复孔。培养48 h后测量450 nm吸光度值。同时以CDDP浓度为16 μg/ml的细胞组中设置时间梯度。继续在同样条件下培养,分别在24、48以及72 h后测量450 nm吸光度值,计算细胞增殖抑制率。细胞增殖抑制率=(1-处理组平均OD值/空白对照组平均OD值)×100%,绘制浓度-抑制率曲线。通过软件(LOGIT法)计算IC50值。
1.2.4 Hoechst法检测shRNA干扰FANCD2对SIHN-005A细胞CDDP作用后凋亡的影响取对数生长期的三组细胞以4 000个每孔分别接种于96孔板,贴壁后吸去多余培养液,加入含CDDP(16 μg/ml)的2.5%FCS DMEM培养液100 μl,继续培养48 h,吸尽培养液,加入0.5 ml固定液固定10 min,PBS洗两遍。0.5 ml Hoechst33258染色液染色5 min。PBS洗两遍。滴一滴抗荧光淬灭封片液于细胞培养孔中,在荧光显微镜下观察各组细胞凋亡形态,采用Image Pro Plus 6.0分析图像,得出各组细胞凋亡分数。
1.2.5 Western blot检测shRNA沉默FANCD2对SIHN-005A细胞相关通路蛋白Bax、Bcl-2、Cyclin D1、HIF-1α表达的影响具体步骤及比较各组Bax、Bcl-2、Cyclin D1、HIF-1α蛋白表达量的方法同1.2.2。
1.3 统计学方法本研究采用SPSS19.0统计软件进行数据处理。计量资料均以均数±标准差(x±s)表示,实验结果数据比较采用单因素方差分析加LSD法两两比较;双侧检验水准α=0.05, P < 0.05为差异有统计学意义。
2 结果 2.1 shRNA干扰抑制FANCD2蛋白的表达Western blot检测结果显示shRNA组条带明显变窄变淡,shRNA组FANCD2蛋白表达灰度值(0.53±0.09)较shRNA-C组(1.15±0.11)(F=78.823, P=0.000)和Control组(1.34±0.07)(F=104.113, P=0.000)明显下降,沉默效率达60.5%,而shRNA-C组与Control组之间差异无统计学意义(F=2.421, P=0.199),见图 1。

|
| 图 1 Western blot检测各组SIHN-005A细胞FANCD2蛋白的表达 Figure 1 Expression of FANCD2 protein in each group of SIHN-005A cells detected by Western blot |
CCK-8实验结果表明同一药物浓度下shRNA-C组和Control组细胞增殖水平基本相同(F=0.862, P=0.380),而shRNA组细胞增殖抑制率较shRNA-C组(F=12.049, P=0.026)和Control组(F=103.859, P=0.001)明显升高,其抑制率随药物浓度的提高而增高,见图 2。16 μg/ml CDDP作用于各组细胞后,其OD值与抑制率随时间增加而增高,并在第48 h开始出现较为明显的抑制作用,具有时间依赖性;其中shRNA组在不同药物浓度作用后48 h其细胞增殖抑制率明显高于shRNA-C组(F=159.960, P=0.000)和Control组(F=68.966, P=0.001),见图 3。shRNA组细胞对CDDP的IC50值(11.5±0.35 μg/ml)明显低于shRNA-C组(18.4±1.11 μg/ml)和Control组(19.9±1.42 μg/ml),提示shRNA组细胞对CDDP的敏感度较shRNA-C组(F=135.153, P=0.000)和Control组(F=200.772, P=0.000)增强。

|
| 图 2 不同浓度CDDP作用于各组SIHN-005A细胞48h细胞增殖抑制率曲线 Figure 2 Proliferation inhibition rate curves of SIHN-005A cells after different concentrations of CDDP administration for 48h |

|
| 图 3 16μg/ml CDDP作用于各组SIHN-005A细胞不同时间的抑制率曲线 Figure 3 Inhibition rate curves of SIHN-005A cells after 16μg/ml CDDP administration at different time points |
Hoechst染色结果显示加入CDDP 16 μg/ml后,shRNA组细胞凋亡率[(85.12±2.03)%]高于shRNA-C组[(17.87±1.63)%]Control组[(11.94±2.42)%],shRNA组与shRNA-C组(F=383.812, P=0.000)及Control组(F=454.839, P=0.000)相比,凋亡率差异有统计学意义,表明经shRNA靶向沉默FANCD2表达能提高人HNSCC SIHN-005A细胞对DNA交联剂CDDP的敏感度,细胞凋亡明显增加,凋亡率较未加CDDP作用更为显著。各组细胞凋亡形态学改变,见图 4。
|
| A: shRNA; B: shRNA-C; C: Control 图 4 CDDP干预后各组SIHN-005A细胞Hoechst33258染色凋亡形态观察 (×200) Figure 4 Apoptosis morphology of SIHN-005A cells after CDDP administration detected by Hoechst33258 staining (×200) |
加用CDDP后,Cyclin D1在shRNA组中的表达显著下调,其灰度值(0.55±0.09)与shRNA-C组(0.89±0.18)(F=54.370, P=0.002)及Control组(0.97±0.24)(F=13.177, P=0.000)比较,差异均有统计学意义,同时加入CDDP后实验组(0.55±0.09)与未加CDDP实验组(0.73±0.11)Cyclin D1比较差异也有统计学意义(F=9.116, P=0.039),见图 5。

|
| *: after CDDP administration 图 5 Western blot检测CDDP作用前后SIHN-005A细胞Cyclin D1蛋白的表达 Figure 5 Expression of Cyclin D1 protein in SIHN-005A cell before and after CDDP administration detected by Western blot |
Western blot检测结果显示加用CDDP后,Bax蛋白在shRNA组中的表达(2.78±0.17)较shRNA-C组(0.93±0.22)(F=249.115, P=0.000)及Control组(0.89±0.16)(F=359.243, P=0.000)明显增强;Bcl-2蛋白加用CDDP后在shRNA组中的表达(0.21±0.07)较shRNA-C组(0.54±0.07)(F=521.732, P=0.000)及Control组(0.79±0.21)(F=26.977, P=0.007)明显抑制;HIF-1α加用CDDP后在shRNA组中的表达(0.60±0.29)较shRNA-C组(1.25±0.56)(F=11.001, P=0.029)及Control组(1.39±0.22)(F=14.563, P=0.019)显著下调(P < 0.05),在加入CDDP实验组与未加CDDP实验组Bax(1.69±0.24)(F=81.348, P=0.001)、Bcl-2(0.63±0.06)(F=227.234, P=0.000)、HIF-1α(1.13±0.32)(F=50.657, P=0.002)蛋白之间比较,差异也均有统计学意义,见图 6。

|
| *: after CDDP administration 图 6 Western blot检测CDDP作用前后SIHN-005A细胞Bcl-2、Bax、HIF-1α蛋白的表达 Figure 6 Expression of Bcl-2, Bax, HIF-1α protein in SIHN-005A cells before and after CDDP administration detected by Western blot |
研究表明FA患者与健康人群相比肿瘤的易患风险提高。FA通路由至少15种FA基因编码的蛋白共同构成,其编码蛋白相互作用构成一个复杂的功能网络,任一基因型的突变都能导致网络功能障碍,进而引起DNA损伤修复功能受损。正常情况下机体暴露于某些诱导基因突变的因素如紫外线及DNA交联剂(丝裂霉素、CDDP)时可启动FA通路对损伤的DNA进行修复,当FA通路由于某些因素被阻断后机体则出现DNA修复功能障碍[5]。FA通路的激活有三个关键环节:FA核心复合体的合成,FANCD2和FANCI的单泛素化,ID复合体和FANCD2-I核灶区的形成。其中,FANCD2的单泛素化在FA通路的激活过程中起着关键作用[6-8]。早在2003年Hölzel等[9]通过免疫组织化学技术在多种人体正常组织中检测到FANCD2的表达,这些组织包括FA患者常见的易癌变组织如头颈部、宫颈鳞状细胞上皮。随后Tremblay等[10-11]研究表明FANCD2的表达缺失及FANCD2去泛素化障碍,可以使FA通路失活进而增加细胞对DNA交联剂的敏感度,然而目前关于FANCD2与头颈肿瘤化疗敏感度的相关研究还较少。
本实验前期运用shRNA干扰技术,靶向作用于人HNSCC SIHN-005A细胞中的FANCD2基因,得到稳定沉默的SIHN-005A FANCD2-shRNA细胞。通过Western blot检测转染组细胞与对照组FANCD2表达情况,确认在转染组中FANCD2表达下调。CCK-8研究结果显示经shRNA干扰沉默FANCD2后,CDDP诱导的细胞增殖活性受到明显抑制,且这一抑制作用呈CDDP浓度和时间依赖性。同时发现实验组细胞的凋亡率明显提高,CDDP化疗后转染组细胞的凋亡率增加更为明显。以上实验说明shRNA干扰技术不仅能敲除目的基因FANCD2,同时经干预后的细胞在CDDP作用后细胞增殖、凋亡等生物学活性方面也发生了明显改变,提示shRNA沉默FANCD2表达增强了HNSCC SIHN-005A细胞对CDDP的敏感度。
CDDP是治疗HNSCC常用的化疗药物,其作用机制主要是抑制DNA复制和RNA转录,使细胞停滞于G1期,并促进其凋亡。因此任何影响细胞CDDP加合物形成与调节细胞凋亡的因素都可以影响细胞对CDDP的敏感度。DNA修复途径中CDDP加合物的过度清除与细胞凋亡途径有关的信号转导通路调节蛋白的错误表达等都与细胞对CDDP的敏感度相关。由此本实验从蛋白水平检测FANCD2 shRNA干扰后细胞周期蛋白Cyclin D1、促凋亡基因Bax和抑制凋亡基因Bcl-2、乏氧诱导因子HIF-1α在三组细胞中的表达。Cyclin D1是作用于G1期重要的细胞周期蛋白,在生长因子的刺激下,G1期Cyclin D1表达并与CDK4、CDK6结合,诱发下游反应促进G1/S期转换而加速细胞周期过程,促进肿瘤细胞的增殖和生长。而G1/S被认为是细胞周期中最为关键的DNA损伤检查点。目前,越来越多的研究更倾向于Cyclin D1作为原癌基因诱发全身多处肿瘤[12-15]。Lee等[16]发现Cyclin D1在甲状腺乳头状癌伴淋巴结转移的患者中存在高表达。而本研究发现shRNA干扰沉默FANCD2后,细胞周期蛋白Cyclin D1表达明显下调,凋亡增加,与前面CCK-8的结果是一致的,且在实验组CDDP作用后下调最为明显。Bcl-2和Bax分别是Bcl-2家族中最具代表性的抑制凋亡基因和促凋亡基因,两者通过控制线粒体膜的通透性来调节凋亡激活物如细胞色素C的释放来影响细胞的位置状态。目前认为Bcl-2抑制凋亡的机制主要有拮抗促凋亡基因Bax、抑制促凋亡的蛋白质细胞色素C自线粒体释放到胞质、阻止胞质中的细胞色素C激活Caspase、抗氧化及维持细胞内钙稳态等作用。Bax/Bcl-2两蛋白之间的比例关系是决定对细胞凋亡抑制作用强弱的关键因素,多数肿瘤的Bcl-2蛋白表达升高而Bax蛋白表达下降。Tanabe等[17]证实将Bcl-2反义寡核苷酸转染入乳腺癌细胞后凋亡率明显增加,肿瘤细胞对化疗药物的敏感度提高。本实验发现shRNA干扰沉默FANCD2后SIHN-005A细胞Bcl-2蛋白表达下调而Bax蛋白表达提高。这与Hoechst法检测shRNA干扰FANCD2对SIHN-005A细胞CDDP作用前后的凋亡结果是一致的。
研究发现在缺氧条件下肿瘤细胞通过上调HIF-1α的表达,促进下游靶基因的转录,包括血管内皮生长因子(vascular endothelial growth factor,VEGF)、促红细胞生成素(erythropoietin,EPO)以及p53等相关作用因子,以适应肿瘤微环境的改变,提高肿瘤细胞的增殖,转移能力和放化疗耐受性[18-20]。国内学者研究发现HIF-1α在鼻咽癌上皮细胞中呈高表达,同时提示高表达的HIF-1α是鼻咽癌患者不良预后及放疗抵抗的关键因子[21]。本实验发现经shRNA干扰沉默FANCD2基因后,HIF-1α表达下调,同时由CDDP诱导的肿瘤细胞凋亡增加、增长抑制。这与Colbert等[22]发现HIF-1α的高表达可以作为胰腺癌肿瘤细胞远处转移敏感度指标的研究结果一致。
综上,shRNA干扰沉默FNACD2表达能提高人HNSCC SIHN-005A细胞对DNA交联剂CDDP的敏感度。其作用机制可能为shRNA沉默FANCD2表达后,下调Cyclin D1、Bcl-2和HIF-1α以及提高Bax表达等方式共同作用而影响SIHN-005A细胞体外生长及化疗敏感度变化,提示FANCD2基因可望成为头颈肿瘤基因治疗的良好靶点,并为FANCD2基因治疗联合化疗提高HNSCC治疗效果提供了实验依据。
| [1] | Kehrli KR, Sidorova JM. Mitomycin C reduces abundance of replication forks but not rates of fork progression in primary and transformed human cells[J]. Oncoscience, 2014, 1(7): 540–55. |
| [2] | Vundinti BR, Korgaonkar S, Ghosh K. Incidence of malignancy and clonal chromosomal abnormalities in Fanconi anemia[J]. Indian J Cancer, 2010, 47(4): 397–9. DOI:10.4103/0019-509X.73575 |
| [3] | Zhu J, Su F, Mukherjee S, et al. FANCD2 influences replication fork processes and genome stability in response to clustered DSBs[J]. Cell Cycle, 2015, 14(12): 1809–22. DOI:10.1080/15384101.2015.1036210 |
| [4] | Raghunandan M, Chaudhury I, Kelich SL, et al. FANCD2, FANCJ and BRCA2 cooperate to promote replication fork recovery independently of the Fanconi Anemia core complex[J]. Cell Cycle, 2015, 14(3): 342–53. DOI:10.4161/15384101.2014.987614 |
| [5] | Auerbach AD. Fanconi anemia and its diagnosis[J]. Mutat Res, 2009, 668(1-2): 4–10. DOI:10.1016/j.mrfmmm.2009.01.013 |
| [6] | Tumini E, Plevani P, Muzi-Falconi M, et al. Physical and functional crosstalk between Fanconi anemia core components and the GINS replication complex[J]. DNA Repair (Amst), 2011, 10(2): 149–58. DOI:10.1016/j.dnarep.2010.10.006 |
| [7] | Sareen A, Chaudhury I, Adams N, et al. Fanconi anemia proteins FANCD2 and FANCI exhibit different DNA damage responses during S-phase[J]. Nucleic Acids Res, 2012, 40(17): 8425–39. DOI:10.1093/nar/gks638 |
| [8] | Sato K, Ishiai M, Toda K, et al. Histone chaperone activity of Fanconi anemia proteins, FANCD2 and FANCI, is required for DNA crosslink repair[J]. EMBO J, 2012, 31(17): 3524–36. DOI:10.1038/emboj.2012.197 |
| [9] | Hölzel M, van Diest PJ, Bier P, et al. FANCD2 protein is expressed in proliferating cells of human tissues that are cancer-prone in Fanconi anaemia[J]. J Pathol, 2003, 201(2): 198–203. DOI:10.1002/path.1450 |
| [10] | Tremblay S, Pintor Dos Reis P, Bradley G, et al. Young patients with oral squamous cell carcinoma: study of the involvement of GSTP1 and deregulation of the Fanconi anemia genes[J]. Arch Otolaryngol Head Neck Surg, 2006, 132(9): 958–66. DOI:10.1001/archotol.132.9.958 |
| [11] | Brown S, Niimi A, Lehmann AR. Ubiquitination and deubiquitination of PCNA in response to stalling of the replication fork[J]. Cell Cycle, 2009, 8(5): 689–92. DOI:10.4161/cc.8.5.7707 |
| [12] | Scantlebury JB, Luo J, Thorstad WL, et al. Cyclin D1-a prognostic marker in oropharyngeal squamous cell carcinoma that is tightly associated with high-risk human papillomavirus status[J]. Hum Pathol, 2013, 44(8): 1672–80. DOI:10.1016/j.humpath.2013.01.021 |
| [13] | Ashrafi M, Bathaie SZ, Abroun S. High Expression of Cyclin D1 and p21 in N-Nitroso-N-Methylurea-Induced Breast Cancer in Wistar Albino Female Rats[J]. Cell J, 2012, 14(3): 193–202. |
| [14] | Bar-Sela G, Hershkovitz D, Haim N, et al. The incidence and prognostic value of HER2 overexpression and cyclin D1 expression in patients with gastric or gastroesophageal junction adenocarcinoma in Israel[J]. Oncol Lett, 2013, 5(2): 559–63. |
| [15] | 韩向春, 康金旺, 郑力强, 等. Wnt1、β-catenin、APC和cyclin D1蛋白在胃癌中的表达[J]. 肿瘤防治研究, 2011, 38(2): 163–6. [ Han XC, Kang JW, Zheng LQ, et al. Expression of Wnt1, β-catenin, APC and cyclin D1 proteins in gastric carcinoma[J]. Zhong Liu Fang Zhi Yan Jiu, 2011, 38(2): 163–6. ] |
| [16] | Lee SH, Lee JK, Jin SM, et al. Expression of cell-cycle regulators (cyclin D1, cyclin E, p27kip1, p57kip2) in papillary thyroid carcinoma[J]. Otolaryngol Head Neck Surg, 2010, 142(3): 332–7. DOI:10.1016/j.otohns.2009.10.050 |
| [17] | Tanabe K, Kim R, Inoue H, et al. Antisense Bcl-2 and HER-2 oligonucleotide treatment of breast cancer cells enhances their sensitivity to anticancer drugs[J]. Int J Oncol, 2003, 22(4): 875–81. |
| [18] | Kim YS, Lee HA, Lim JY, et al. β-Carotene inhibits neuroblastoma cell invasion and metastasis in vitro and in vivo by decreasing level of hypoxia-inducible factor-1α[J]. J Nutr Biochem, 2014, 25(6): 655–64. DOI:10.1016/j.jnutbio.2014.02.006 |
| [19] | 景绍武, 王雅棣, 郑明民, 等. HIF-1α对食管癌Eca109细胞体内外侵袭转移的影响及其分子机制[J]. 细胞与分子免疫学杂志, 2012, 28(1): 67–71. [ Jing SW, Wang YD, Zheng MM, et al. Effect of HIF-1ɑ and its mechanism on invasion and metastasis of esophageal carcinoma Eca109 cells in vitro and in vivo[J]. Xi Bao Yu Fen Zi Mian Yi Xue Za Zhi, 2012, 28(1): 67–71. ] |
| [20] | Semenza GL. O2-regulated gene expression: transcriptional control of cardiorespiratory physiologe by HIF-1[J]. J Appl Physiol (1985), 2004, 96(3): 1173–7. |
| [21] | Wan XB, Fan XJ, Huang PY, et al. Aurora-A activation, correlated with hypoxia-inducible factor-1alpha, promotes radiochemoresistance and predicts poor outcome for nasopharyngeal carcinoma[J]. Cancer Sci, 2012, 103(8): 1586–94. DOI:10.1111/j.1349-7006.2012.02332.x |
| [22] | Colbert LE, Fisher SB, Balci S, et al. High nuclear hypoxia-inducible factor 1 alpha expression is a predictor of distant recurrence in patients with resected pancreatic adenocarcinoma[J]. Int J Radiat Oncol Biol Phys, 2015, 91(3): 631–9. DOI:10.1016/j.ijrobp.2014.11.004 |
 2017, Vol. 44
2017, Vol. 44


